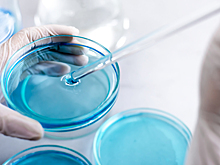
Разум из пробирки: возможно ли вырастить искусственный мозг

Научпоп5 сентября


Научпоп3 сентября5

Научпоп2 сентября1

Научпоп29 августа1

Научпоп28 августа

Научпоп27 августа


Научпоп23 августа

Научпоп22 августа

Научпоп19 августа1

Научпоп18 августа

Научпоп15 августа

Научпоп13 августа4

Научпоп12 августа

Научпоп12 августа1

Научпоп11 августа


Научпоп6 августа3

Научпоп5 августа

Научпоп5 августа3

Научпоп4 августа

Научпоп2 августа2

Научпоп30 июля1

Научпоп29 июля6

Научпоп22 июля

Научпоп17 июля